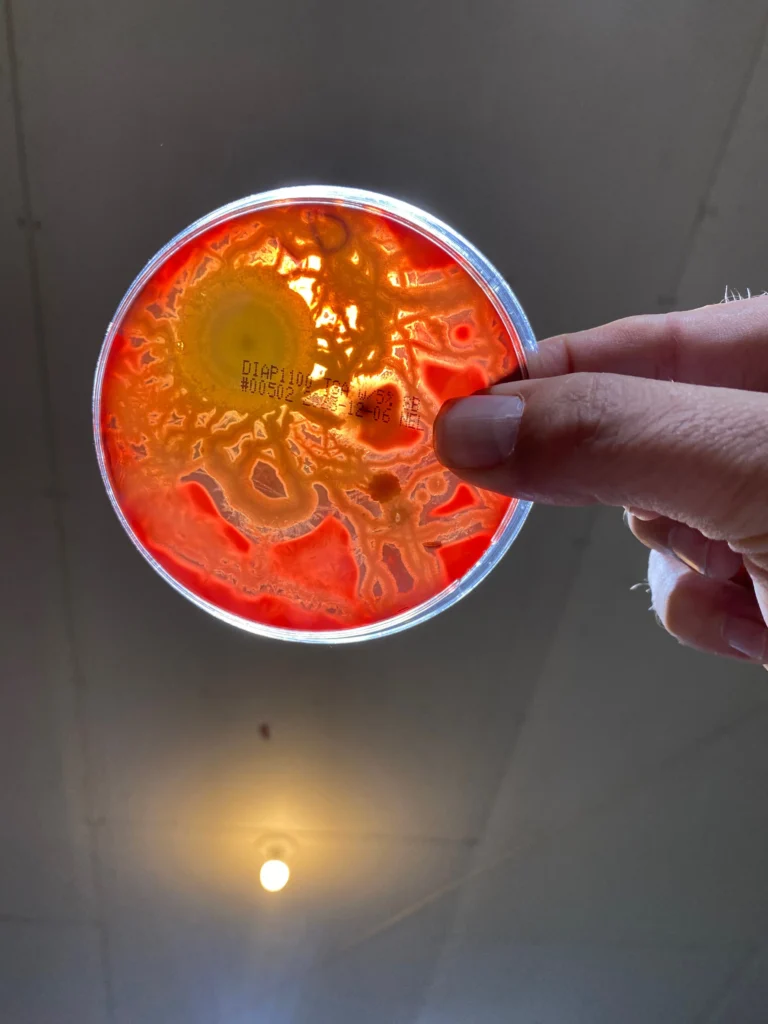

Wellness Center Disinfection in Sheboygan, WI
Wellness centers, spas, gyms, and fitness studios host a variety of clients daily, creating high-contact surfaces and shared environments where pathogens can easily spread. HS Ultra provides advanced, chemical-free disinfection solutions across Sheboygan, WI and throughout Wisconsin to keep wellness spaces safe and hygienic. Utilizing UV-C disinfection, aqueous ozone cleaning, and gaseous ozone fumigation, we deliver comprehensive pathogen control while maintaining a safe and comfortable environment for clients and staff. Our services protect against bacteria, viruses, mold, and odors, supporting healthier air quality, safer exercise areas, and reduced cross-contamination.
Contact Us


Tailored Solutions for Wellness Facilities
Comprehensive Disinfection Services
HS Ultra creates customized disinfection programs specifically for wellness centers, spas, gyms, and studios. From routine surface cleaning with aqueous ozone to periodic UV-C room and HVAC treatments, our approach ensures all equipment, treatment rooms, locker areas, and high-traffic zones remain sanitized. Gaseous ozone fumigation can be used for deep cleans during off-hours or for emergency pathogen resets, providing a thorough, chemical-free solution. We focus on sustainable, hands-free methods that maintain the wellness center’s ambiance while delivering measurable sanitation results.
Why Disinfection is Critical for Wellness Centers
Wellness centers are hubs for client health and relaxation, but the high turnover of patrons and frequent equipment use increase the risk of pathogen spread. HS Ultra’s chemical-free disinfection solutions not only reduce harmful microbial loads but also improve indoor air quality, minimize odors, and create a safer environment for immunocompromised clients or those with allergies. Our expert team implements recurring disinfection schedules and consults on hygiene best practices, ensuring wellness centers maintain regulatory compliance and operational efficiency while giving clients confidence in the cleanliness and safety of the facility.
Trusted Disinfection Solutions
Key Benefits of Partnering with HS Ultra
Comprehensive Surface & Air Pathogen Control
UV-C systems, HVAC retrofits, and aqueous ozone applications eliminate bacteria, viruses, mold, and odors, creating a safer experience for clients and staff.
Safe, Chemical-Free Disinfection
Our methods replace harsh chemical sanitizers, reducing exposure risks for sensitive individuals while maintaining effective sanitation across equipment, treatment rooms, and communal spaces.
Custom Programs for Long-Term Hygiene
Recurring service plans, staff training, and emergency ozone treatments ensure wellness centers remain protected, supporting consistent pathogen control, client satisfaction, and compliance with health regulations.

Our Commercial Solutions
Tailored. Measurable. Chemical-Free.
Explore our specialized services designed for businesses, facilities, and critical industries. Each solution is built for performance, safety, and long-term results.
Custom Consulting & Installations
UV-C Air & Surface Disinfection
Aqueous Ozone Applications
Gaseous Ozone Fumigation
Our ozone gas treatments saturate the airspace and reach deep into HVAC ducts, equipment, and porous surfaces—destroying mold, bacteria, and viruses at the molecular level. Ideal for deep resets in food plants, labs, animal care, or buildings with persistent odor or contamination issues.
Proven Results from Real-World Application
Daycare Study: A New Standard in Childcare Disinfection
See the Science at Work
Before & After: Surface Test Plate Results






